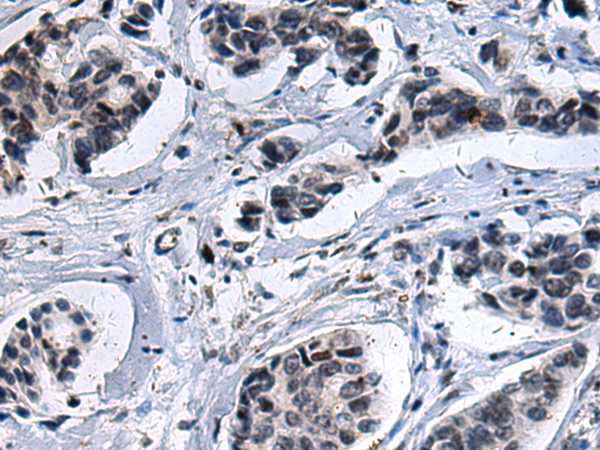

中文名稱 : 兔抗ZFAND2B多克隆抗體
技術(shù)規(guī)格
Background:
This gene encodes a protein containing AN1-type zinc-fingers and ubiquitin-interacting motifs. The encoded protein likely associates with the proteosome to stimulate the degradation of toxic or misfolded proteins. Alternatively spliced transcript variants encoding multiple isoforms have been observed for this gene.
Applications:
ELISA, WB
Name of antibody:
ZFAND2B
Immunogen:
Synthetic peptide of human ZFAND2B
Full name:
zinc finger, AN1-type domain 2B
Synonyms:
AIRAPL
SwissProt:
Q8WV99
ELISA Recommended dilution:
1000-2000
WB Predicted band size:
28 kDa
WB Positive control:
Mouse brain tissue
WB Recommended dilution:
200-1000

購物車
購物車 幫助
幫助
 021-54845833/15800441009
021-54845833/15800441009
